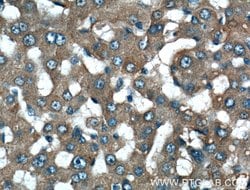
Fibrinogen alpha chain Rabbit anti-Human, Mouse, Polyclonal, Proteintech:Antibodies:Primary

missing translation for 'onlineSavingsMsg'
Learn More
Learn More
Fibrinogen alpha chain Rabbit anti-Human, Mouse, Polyclonal, Proteintech
Rabbit Polyclonal Antibody
£135.00 - £349.00
Specifications
| Antigen | Fibrinogen alpha chain |
|---|---|
| Concentration | 0.35 mg/mL |
| Applications | Immunohistochemistry (Paraffin), Western Blot |
| Classification | Polyclonal |
| Conjugate | Unconjugated |
Description
Fibrinogen is a soluble protein found in blood plasma and is produced by the liver cells. The protein is a hexamer consisting of two sets of disulfide linked chains. Fibrinogen is essential for blood coagulation as the precursor of fibrin. It is converted to fibrin by the action of thrombin in the presence of calcium ions.Specifications
| Fibrinogen alpha chain | |
| Immunohistochemistry (Paraffin), Western Blot | |
| Unconjugated | |
| Rabbit | |
| Mouse, Human | |
| E9PV24, P02671 | |
| 14161, 2243 | |
| Fibrinogen alpha chain Fusion Protein Ag9567 | |
| Primary | |
| -20°C | |
| FGA |
| 0.35 mg/mL | |
| Polyclonal | |
| Liquid | |
| RUO | |
| PBS with 50% glycerol and 0.1% sodium azide; pH 7.3 | |
| FGA, Fib2, fibrinogen alpha chain | |
| Fga | |
| IgG | |
| Antigen Affinity Chromatography | |
| Antibody |
Spot an opportunity for improvement?Share a Content Correction
Product Content Correction
Your input is important to us. Please complete this form to provide feedback related to the content on this product.
Product Title